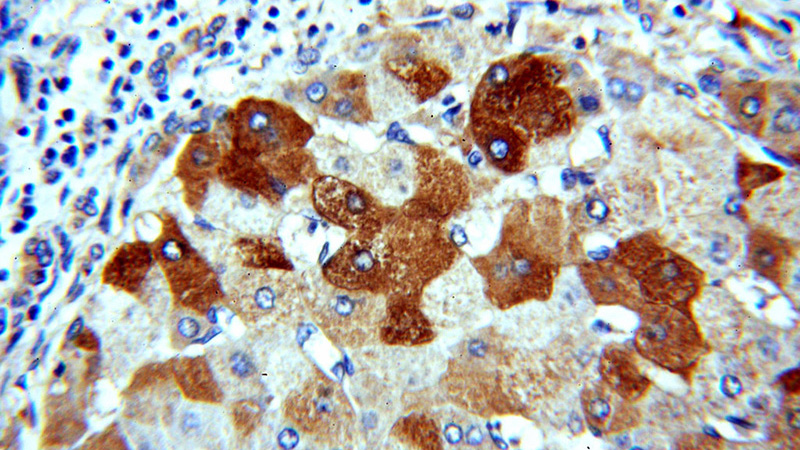
Immunohistochemical of paraffin-embedded human hepatocirrhosis using Catalog No:111326(H6PD antibody) at dilution of 1:100 (under 40x lens)

-
Product Name
H6PD antibody
- Documents
-
Description
H6PD Rabbit Polyclonal antibody. Positive IP detected in HepG2 cells. Positive WB detected in HepG2 cells, HeLa cells, mouse liver tissue. Positive IHC detected in human hepat℃irrhosis tissue, human liver cancer tissue. Observed molecular weight by Western-blot: 89-95 kDa
-
Tested applications
ELISA, IHC, WB, IP
-
Species reactivity
Human,Mouse,Rat; other species not tested.
-
Alternative names
6PGL antibody; DKFZp686A01246 antibody; G6PDH antibody; GDH antibody; H6PD antibody
-
Isotype
Rabbit IgG
-
Preparation
This antibody was obtained by immunization of H6PD recombinant protein (Accession Number: XM_017002865). Purification method: Antigen affinity purified.
-
Clonality
Polyclonal
-
Formulation
PBS with 0.02% sodium azide and 50% glycerol pH 7.3.
-
Storage instructions
Store at -20℃. DO NOT ALIQUOT
-
Applications
Recommended Dilution:
WB: 1:500-1:5000
IP: 1:500-1:5000
IHC: 1:20-1:200
-
Validations

Immunohistochemical of paraffin-embedded human hepatocirrhosis using Catalog No:111326(H6PD antibody) at dilution of 1:100 (under 10x lens)
Immunohistochemical of paraffin-embedded human hepatocirrhosis using Catalog No:111326(H6PD antibody) at dilution of 1:100 (under 40x lens)

HepG2 cells were subjected to SDS PAGE followed by western blot with Catalog No:111326(H6PD Antibody) at dilution of 1:1000

IP Result of anti-H6PD (IP:Catalog No:111326, 4ug; Detection:Catalog No:111326 1:1000) with HepG2 cells lysate 1600ug.
-
Background
Hexose-6-phosphate dehydrogenase (H6PD) is also named as GDH,6PGL. It is the main NADPH generating enzyme in the lumen of the endoplasmic reticulum. H6PD is regarded as an ancillary enzyme in prereceptorial glucocorticoid activation and probably acts as a nutrient sensor and as a prosurvival factor(PMID:21620971). H6PD has been shown to be a glycoprotein and tissue differences in glycosylation status might explain both the difference in migration on SDS-PAGE gels as well as in activity. Defects in H6PD are a cause of cortisone reductase deficiency (CRD). This antibody is specific to H6PD.
Related Products / Services
Please note: All products are "FOR RESEARCH USE ONLY AND ARE NOT INTENDED FOR DIAGNOSTIC OR THERAPEUTIC USE"
